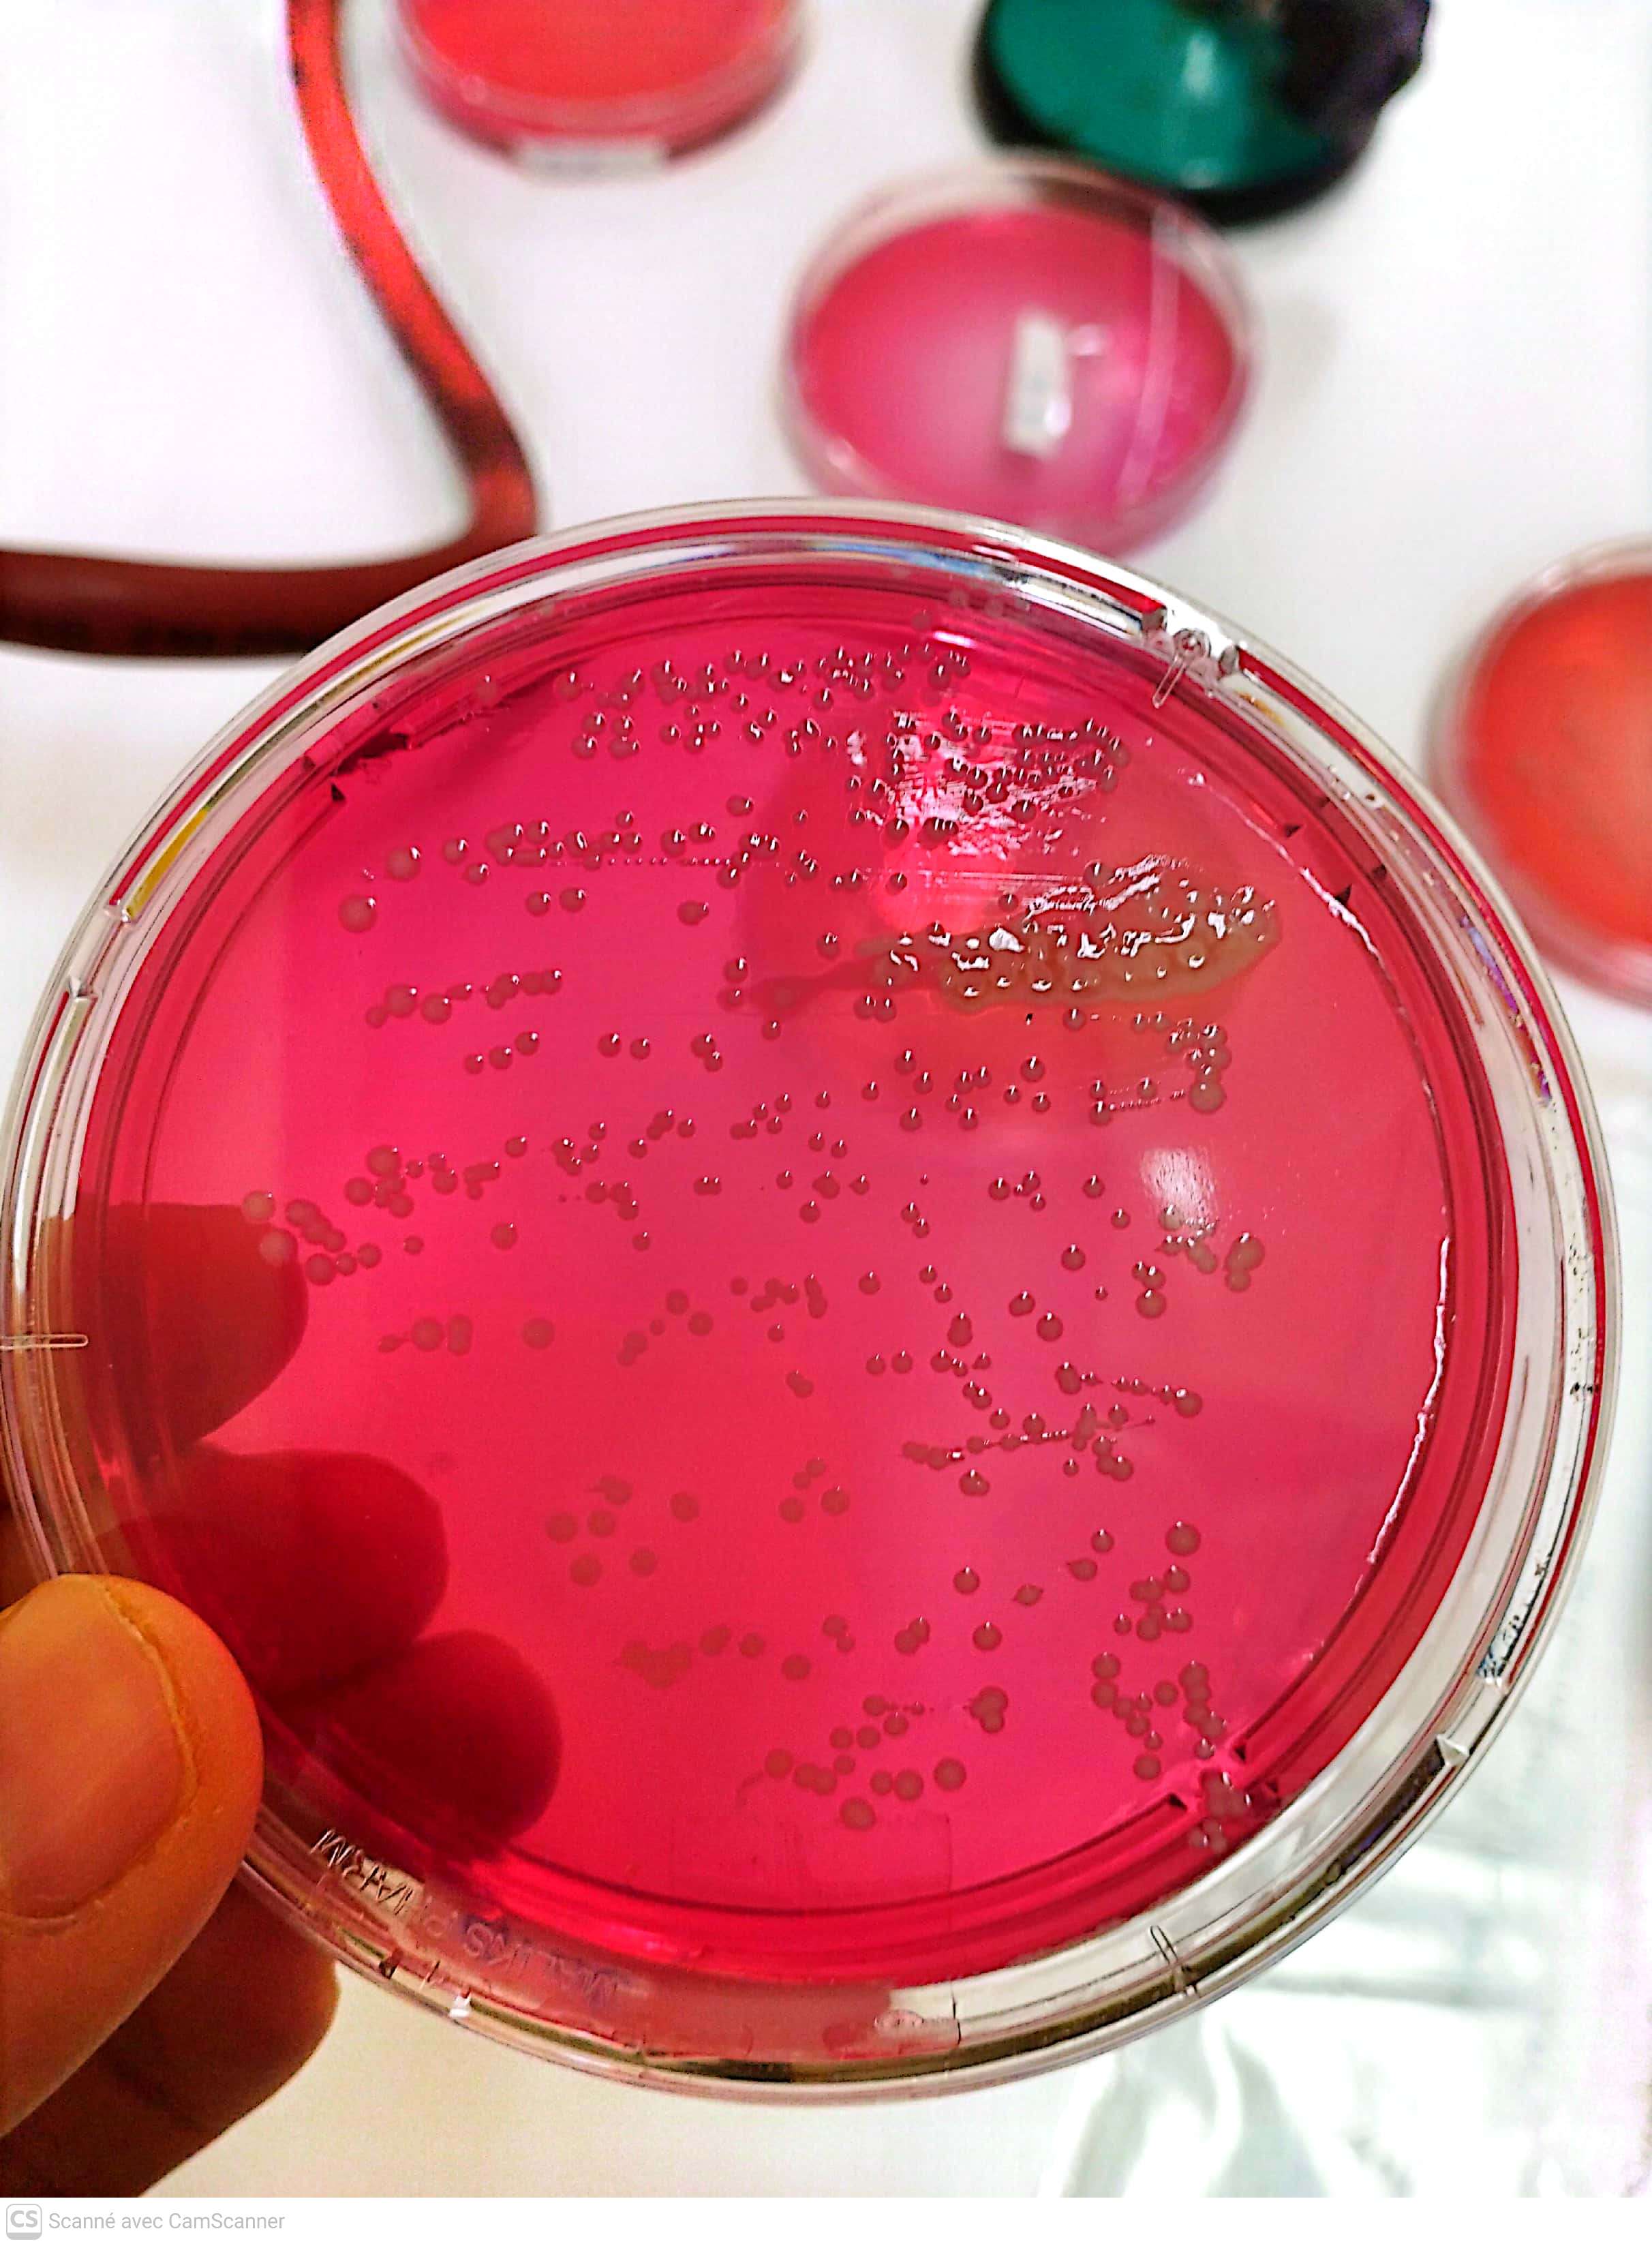

Ce module a pour objectif de développer les compétences de base en communication orale. Il permet aux étudiants de maîtriser les principes fondamentaux de la communication, les différentes formes d’expression orale et les techniques de prise de parole en public. À travers des activités pratiques et interactives, les étudiants améliorent leur capacité d’argumentation, d’écoute active et de communication efficace en groupe, tout en utilisant des outils de présentation adaptés au contexte académique et professionnel.
- Enseignant: chaima labadla

Sensory evaluation is a scientific method used to study food characteristics using the human senses (sight, smell, taste, touch, and hearing). It is important in food science because it helps evaluate consumer acceptability, improve product quality, and support product development. Sensory evaluation also has economic importance, as it reduces market risks and increases product success.
Sensory perception results from the detection of food stimuli by sensory receptors and their interpretation by the brain. The five senses contribute to the perception of color, aroma, taste, texture, and sound, and individual, psychological, and environmental factors can influence this perception.
Sensory tests include discriminative tests to detect differences, descriptive tests to describe sensory attributes, and affective tests to measure consumer preference. Statistical analysis is used to determine whether observed differences are significant and reliable.
- Enseignant: Yasmine Taleb

Process engineering brings together the scientific and technological knowledge needed to transform raw materials—through physicochemical and biological processes—into formulated products for consumers.
In food engineering, this is often approached through unit operations, where a process is broken down into a sequence of basic steps depending on the goal and the material being treated. This approach supports process design, scaling-up, flow diagram development, and the production of stable, high-quality products at lower cost. In this module, the content is organized according to the classification of unit operations.
This course follows the official syllabus and provides a clear reference for students. It is based on my teaching experience and includes detailed lessons, solved examples, and additional exercises, written in a simple and accessible style.
- Enseignant: Imane Kouadri

Food biochemistry is the study of the chemical and biological processes that occur in food. It is a multidisciplinary field that encompasses aspects of chemistry, biology, microbiology, and engineering. Food biochemistry is used to understand the nutritional value of food, the effects of processing on food, and the causes of food spoilage.
The Food Biochemistry course is a fascinating and in-depth exploration of the chemical processes and reactions that occur in food and its components. This course delves into the molecular structures, interactions, and transformations that take place during food processing, storage, and consumption. With a strong emphasis on the scientific principles underlying food composition, nutritional value, and quality, this course provides a solid foundation for understanding the intricate relationship between food and biochemistry.
- Enseignant: insaf malek
Le cours de microbiologie générale présente les fondements scientifiques liés à l’étude des micro-organismes, notamment les bactéries, les champignons microscopiques, les virus et certaines algues et protozoaires. Il aborde leur organisation cellulaire, leur physiologie, leurs modes de croissance et de reproduction, ainsi que les méthodes de culture, d’isolement, d’identification et de contrôle. Le cours traite également des interactions entre micro-organismes et environnement, de leur rôle dans les écosystèmes, l’industrie et la santé humaine. L’objectif principal est de fournir aux étudiants une compréhension solide des principes microbiologiques afin de leur permettre d’appliquer ces connaissances en laboratoire, en analyse microbiologique et dans divers domaines biomédicaux, industriels et environnementaux.
- Enseignant: FATMA DJAMAA